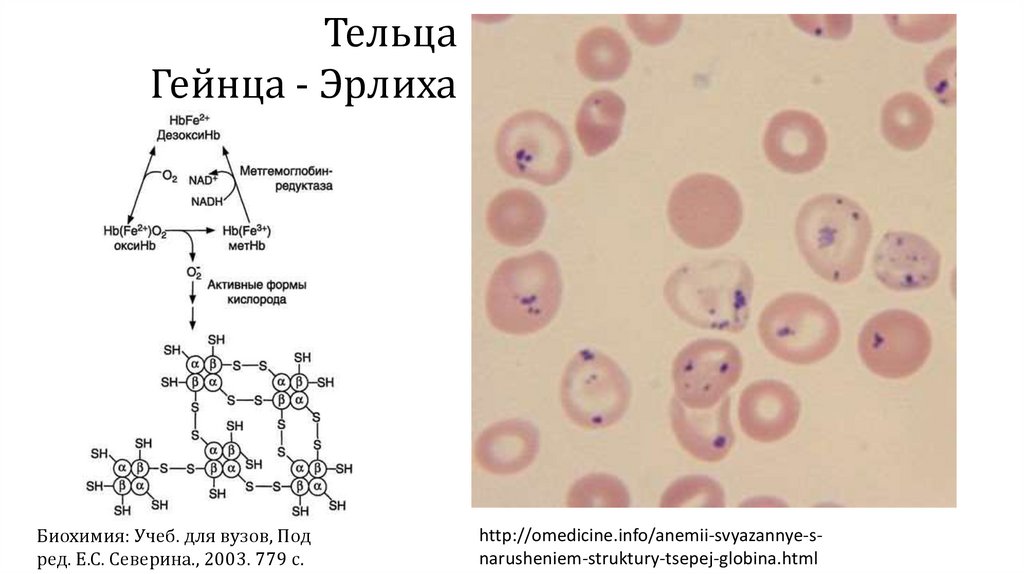

Похожие презентации:
Хромопротеиды (от. греч. chroma — цвет, окраска + протеиды)
1.
Хромопротеиды(от. греч. chroma — цвет, окраска + протеиды) –
сложные белки, простетическая группа которых
окрашена
Железосодержащие порфиринпротеины (гемопротеины)
Флавопротеины (содержащие ФАД или ФМН)
Ретинальпротеины (содержат производные витамина А)
Кобаламинпротеиды (содержат производные витамина В12)
2.
1.2.
3.
4.
5.
6.
7.
8.
9.
10.
11.
12.
13.
Гемопротеиды
Гемоглобин
Миоглобин
Цитохромы
Сукцинатдегидрогеназа
Каталаза
Миелопероксидаза
Гуанилатциклаза
NO-синтазы
Циклооксигеназы
Тиреопероксидаза
Гомогентизатоксидаза
Нейроглобин
Цитоглобин
Гемы (от др.-греч. ἁίμα — «кровь») —
комплексные соединения порфиринов с
железом
гем B
https://ru.wikipedia.org/wiki/Гем_(биохимия)
3.
4.
Цитохром С - оксидазаБактерии
О
А
В
Гемоглобин
Комплекс III
Миоглобин
Цитохром С
NO-синтазы
Циклооксигеназы
Цитохром Р450
С
5.
Известен ряд различных гемов, отличающихсязаместителями порфиринового ядра:
Гем
Гемопротеины
Заместитель при
С3
С8
С18
А
В
—CH(OH)CH2Far
—CH=CH2
—CH=O
Цитохром С - оксидаза
—CH=CH2
—CH=CH2
—CH3
С
—CH(цистеин-S-ил)CH3 —CH(цистеин-S-ил)CH3 —CH3
О
—CH(OH)CH2Far
Гемоглобин
Миоглобин
NO-синтазы
Циклооксигеназы
Цитохром Р450
Комплекс
III
ДЦ
митохондрий
Цитохром С
У человека не выявлен
используется
бактериями. Например,
E. coli.
—CH=CH2
—CH3
6.
NO-синтазаЦитохром
Каталаза
Пероксидаза
Миелопероксидаза
ЦОГ
https://ru.wikipedia.org/wiki/Заглавная_страница
Миоглобин
Нейроглобин
7.
https://inet-health.ru/wp-content/uploads/2017/01/gemoglobin4.jpghttps://encrypted-tbn0.gstatic.com/images?q=tbn:ANd9GcRH9ZufGrYxGYJbbXXDYFqeF936uwhZESYSiFRyPfHdHLfF7Xod
8.
Гемоглобин — гемопротеин, содержащийся в эритроцитах, способныйобратимо связываться с кислородом, обеспечивая его перенос в ткани
Растворимость O2 в воде (н. у.): 4,9 мл / 100 мл.
Ежедневная средняя потребность человека в
газообразном O2 ≈600 л
Гемоглобин, содержащийся в 100 мл крови,
связывает ≈ 20 мл O2
146 аминокислот
Mr ≈ 66,8 кДа
146 аминокислот
В одном эритроците среднего размера
(7 мкм) содержится 15–20 мкг
гемоглобина (35% массы эритроцита)
«Почетный фермент»
Размер молекулы ≈ 3,6 нм
pI=6,8
Высокое содержание гистидина
Гем – 4% молекулы
Глобин – 96% молекулы
141 аминокислота
141 аминокислота
9.
Тетрамер гемоглобина – сфероиддлиной 64Å,
шириной 55Å
высотой 50Å
Стабилизация субъединиц:
водородные, ионные, гидрофобные связи
Неполярные гидрофобные связи, обращенные внутрь
белка, играют главную роль в стабилизации
четвертичной структуры гемоглобина
Гемовая группа локализована в
гидрофобном «гемовом кармане»
каждой из четырёх субъединиц
10.
Сечение областигемового кармана
миоглобина
Шайтан К. В., Шайтан К. В. Диффузия лигандов в белках //СОЖ. – 2000. – №. 6. – С. 8.
11.
Шайтан К. В., Шайтан К. В. Диффузия лигандов в белках //СОЖ. – 2000. – №. 6. – С. 8.Одна из координационных связей железа соединена с остатком
гистидина, таким образом осуществляется связь белка с гемом
[Биохимия: Учеб. для вузов, Под ред. Е.С. Северина., 2003. 779 с.].
12.
http://www.sbras.info/articles/education/gruzovik-dlya-kisloroda13.
«Втягивание» оксигенированного Fe2+ в область пиррольных колец приоксигенировании
[Биохимия: Учеб. для вузов, Под ред. Е.С. Северина., 2003. 779 с.].
14.
Молекула может существовать в двух конформациях: T- и R- формах (одна хорошоотдает, другая – связывает кислород)
http://www.sbras.info/articles/education/gruzovik-dlya-kisloroda
https://pdb101.rcsb.org/motm/41
15.
Первая молекулакислорода
присоединяется к
гемоглобину
в 200 раз медленнее,
чем четвертая
Биохимия: Учеб. для вузов, Под ред. Е.С. Северина.,
2003. 779 с.
Страйер Л. Биохимия: Пер. с англ.-М.: Мир,
1984.-Т.1 - 232 с.
16.
17.
Кривая насыщения гемоглобина кислородом. Более высокое сродство к кислороду умиоглобина по сравнению с гемоглобином: миоглобин в мышцах забирает кислород из
крови
[Страйер Л. Биохимия: Пер. с англ.-М.: Мир, 1984.-Т.1 - 232 с.].
18.
Сатурация крови кислородом (SpO2) - усредненный процент насыщениямолекулами кислорода молекул гемоглобина. При 100% сатурации условно
говорят о наличии четырех присоединённых молекул кислорода к каждой из
молекул гемоглобина
http://www.thermometerguide.com
http://www.pocvoda.ru/product/neonatalmonitor-star8000b-58.html
19.
рО2рСО2
рН
2,3-бфг
Температура
20.
Эффект Бора (Вериго - Бора) - увеличение освобождения О2 гемоглобиномв зависимости от концентрации Н+(СО2) .
Эффект открыт независимо друг от друга
Б. Ф. Вериго (1892) и К. Бором (1904).
Транспорт СО2 в крови
Биохимия: Учеб. для вузов, Под ред. Е.С. Северина., 2003. 779 с.
21.
Шунт Рапопорта Люберинга(2,3-дифосфоглицератный
шунт) в эритроцитах
Взаимодействие 2,3бифосфоглицерата с
аминокислотными
остатками центральной
полости дезоксигемоглобина
Ленинджер А. Основы биохимии: В 3-х т. Т. 1. Пер. с
англ.-М.: Мир, 1985.-367 с.
22.
ПРОИЗВОДНЫЕ ГЕМОГЛОБИНАФункциональные (нормальные) формы Hb
2+
ННbFe О2 Оксигемоглобин
гемоглобин, присоединивший О2
ННb
2+
Fe Дезоксигемоглобин
(восстановленный, редуцированный, феррогемоглобин), отдавший О2
ННb Fe2+ СО2 Карбогемоглобин
через аминогруппы
связывается с СО2, благодаря чему переносится от 10 до 20% всего
транспортируемого кровью СО2
23.
КарбоксигемоглобинННb
2+
Fe СО
https://sibac.info/conf/naturscience/xviii/38210
http://22.mchs.gov.ru/upload/site67/document_news/aUx1rZp55N-bigreduce350.jpg
24.
МетгемоглобинМетгемоглобинобразователи:
Бертолетова соль
Нитриты (азотистокислые соли натрия)
Анилин
Динитробензол
Нитроглицерин
Сульфаниламиды
3-15% – появляется характерный оттенок кожи
15-20 % – цианоз
25-50% – мигрень, слабость, одышка, боль в груди, спутанность
сознания.
50-70% – обмороки, галлюцинации, судороги, кома.
более 70% – летальный исход
ННb
3+
Fe
25.
ТельцаГейнца - Эрлиха
Биохимия: Учеб. для вузов, Под
ред. Е.С. Северина., 2003. 779 с.
http://omedicine.info/anemii-svyazannye-snarusheniem-struktury-tsepej-globina.html
26.
Метгемоглобин - антицианидhttps://upload.wikimedia.org/wikipedia/commons/thumb/a/ab/Cytochrome_C_Oxidase_1OCC_in_Membrane_2.png/800pxCytochrome_C_Oxidase_1OCC_in_Membrane_2.png
27.
28.
Возраст, полУровень гемоглобина, г/дл
1 день - 14 дней
14 дней - 4,3 недели
4,3 недели - 8,6 недель
8,6 недель - 4 месяца
4 месяца - 6 месяцев
6 месяцев - 9 месяцев
9 месяцев - 12 месяцев
12 месяцев - 5 лет
5 лет - 10 лет
10 лет - 12 лет
12 лет - 15 лет
15 лет - 18 лет
18 лет - 45 лет
45 лет - 65 лет
> 65 лет
Женщины
Мужчины
Женщины
Мужчины
Женщины
Мужчины
Женщины
Мужчины
Женщины
Мужчины
13,4 - 19,8
10,7 - 17,1
9,4 - 13,0
10,3 - 14,1
11,1 - 14,1
11,4 - 14,0
11,3 - 14,1
11,0 - 14,0
11,5 - 14,5
12,0 - 15,0
11,5 - 15,0
12,0 - 16,0
11,7 - 15,3
11,7 - 16,6
11,7 - 15,5
13,2 - 17,3
11,7 - 16,0
13,1 - 17,2
11,7 - 16,1
12,6 - 17,4
Информация с сайта https://www.invitro.ru
29.
Типы гемоглобинов человекаСовременная номенклатура типов гемоглобина была принята
Международном гематологическом конгрессе в Стокгольме в 1964 г.
на
Х
Типы гемоглобина обозначают буквами латинского алфавита от А до G и S
Для обозначения новых гемоглобинов не рекомендуется использовать
остальные буквы алфавита – их называют по месту открытия
Полипептидные цепи гемоглобинов обозначаются греческими буквами
Все многообразие типов гемоглобина можно разделить:
– на постоянно присутствующие в крови человека (HbА1, HbА2)
– появляющиеся только на определенных этапах развития организма (HbP, HbF )
– патологические формы (HbS, HbC, HbE и др.)
Кривенцев Ю. А., Бисалиева Р. А., Носков А. И. Гемоглобины человека //Вестник Астраханского
государственного технического университета. – 2007. – №. 6.
30.
Типы гемоглобинов человекаГемоглобин А 2 2
(от лат. adultus — взрослый) – основной гемоглобин взрослого
организма, около 98% от общего количества гемоглобина
Гемоглобин А2 2 2
2 - 3% гемоглобина («медленный» Hb)
Гемоглобин E (Р) ζ и ε
Эмбриональные типы гемоглобина
1-6 недели внутриутробного развития:
Gower 1 - ζ2ε2,
Gower 2 - α2ε2,
Portland 2 - ζ2β2
31.
Гемоглобин F 2α2γC 6 недели внутриутробного развития до рождения
с 25 по 105 день после рождения уровень HbF снижается до
безопасного для взрослого человека значения — не больше 1 % от
общего количества вещества в крови
Повышение
после 105 дня возможно при:
талассемиях
гемолитических анемиях
железодефицитной анемии
лейкозах
гипопластической анемии
32.
Смена гемоглобинов впроцессе индивидуального
развития
Топунов А. Ф., Петрова Н. Э. Гемоглобины: эволюция,
распространение и гетерогенность //Успехи биол. химии. –
2001. – Т. 41. – С. 199-228.
33.
Типы гемоглобинов человекаПомимо физиологических типов Hb, в настоящее время известно около 200
патологических его вариантов
Наличие в эритроцитах людей аномальных или патологических гемоглобинов
определяет состояния, обозначаемые как гемоглобинозы или
гемоглобинопатии. Это наследственные аномалии кроветворения, при которых
молекулы патологических гемоглобинов имеют измененную структуру,
поэтому подобные заболевания относятся к группе так называемых
молекулярных болезней.
Причиной возникновения патологических Hb является повреждение генов,
отвечающих за синтез той или иной цепи гемоглобина (α, β, γ, ε).
Патологические типы гемоглобина, как и нормальные, различаются не по
структуре протопорфиринового кольца, а по строению глобина.
HbS(B),HbC, HbD, HbE, HbG, HbH, HbI, HbJ, HbK, HbL, HbM, HbN, HbO, HbP, HbQ, Hb-Бартс
Кривенцев Ю. А., Бисалиева Р. А., Носков А. И. Гемоглобины человека //Вестник Астраханского
государственного технического университета. – 2007. – №. 6.
34.
Аномальные гемоглобины, в которых замещеныаминокислотные остатки в области, сближенной с гемом
Кривенцев Ю. А., Бисалиева Р. А., Носков А. И. Гемоглобины человека //Вестник Астраханского
государственного технического университета. – 2007. – №. 6.
35.
ТалассемииГруппа врожденных микроцитарных
гемолитических анемий, которые
характеризуются дефектом синтеза
гемоглобина.
Альфа-талассемия распространена
среди лиц африканского,
средиземноморского, или
южноазиатского происхождения.
Бета-талассемия распространена у
лиц средиземноморского,
ближневосточного, южноазиатского
и индийского происхождения.
Анемия, гемолиз, спленомегалия,
гиперплазия костного мозга, при
многократных гемотрансфузиях
может наблюдаться перегрузка
железом.
Лохматова М. Е., Сметанина Н. С., Финогенова Н. А.
Эпидемиология гемоглобинопатий в Москве //Педиатрия.
Журнал им. ГН Сперанского. – 2009. – Т. 87. – №. 4.
36.
Лохматова М. Е., Сметанина Н. С., Финогенова Н. А. Эпидемиологиягемоглобинопатий в Москве //Педиатрия. Журнал им. ГН Сперанского. – 2009. – Т.
87. – №. 4.
Жиленкова Ю. И., Пшеничная К. И., Ивашикина Т. М. Распространённость
гемоглобинопатий среди детей г. Санкт-Петербурга //Медицинский алфавит.
– 2015. – Т. 1. – №. 2. – С. 29-31.
37.
https://pbs.twimg.com/media/Dm6lFprXgAUcszk?format=jp
g&name=small
38.
Keren D. F. et al. Comparison of Sebia Capillarys capillary electrophoresis with the Primus high-pressure liquid chromatography in the evaluationof hemoglobinopathies //American journal of clinical pathology. – 2008. – Т. 130. – №. 5. – С. 824-831.
39.
HbA1С Гликированный гемоглобинСоединение гемоглобина с глюкозой.
Образуется в результате медленного
неферментативного присоединения глюкозы к
гемоглобину А, содержащемуся в эритроцитах.
В соответствии с рекомендациями ВОЗ признан
оптимальным и необходимым для контроля
сахарного диабета.
http://www.sebia.com/en-EN/produits/capi-3-hb-a1c
40.
Karow D. S. et al. Spectroscopiccharacterization of the soluble guanylate
cyclase-like heme domains from Vibrio
cholerae and Thermoanaerobacter
tengcongensis //Biochemistry. – 2004. – Т. 43.
– №. 31. – С. 10203-10211.
VCA0720 forms stable
complexes with NO and CO but not with O2 and therefore
has ligand-binding properties similar to those of the NO
receptor soluble
guanylate cyclase. TtTar4H, on the other hand, is isolated
as a ferrous-oxy complex and has spectral properties
similar to those of the
globin family and, like the globins, forms stable complexes
with NO and CO.
41.
Boehme J. et al. Preservation ofmyocardial contractility during
acute hypoxia with OMX-CV, a
novel oxygen delivery
biotherapeutic //PLoS biology. –
2018. – Т. 16. – №. 10. – С.
e2005924.
42.
Перфторанhttps://ru.wikipedia.org/wiki/Перфторан
https://www.rlsnet.ru/tn_index_id_6209.htm
https://www.m24.ru/articles/nauka/21012015/64542
http://vivovoco.astronet.ru/VV/JOURNAL/VRAN/PF/PERFTOR.HTM
http://www.ng.ru/science/2004-02-25/13_blood.html
https://nasledie.pravda.ru/1105417-belojarzev/
https://ru.wikipedia.org/wiki/Белоярцев,_Феликс_Фёдорович
https://tvkultura.ru/video/show/brand_id/20954/episode_id/1151468/video_id/1109921/
https://www.youtube.com/watch?v=_APmLCGrS5c
43.
1.2.
3.
4.
5.
6.
7.
8.
9.
10.
11.
12.
13.
Гемопротеиды
Гемоглобин
Миоглобин
Цитохромы
Сукцинатдегидрогеназа
Каталаза
Миелопероксидаза
Гуанилатциклаза
NO-синтазы
Циклооксигеназы
Тиреопероксидаза
Гомогентизатоксидаза
Нейроглобин
Цитоглобин
гем B
Гемы (от др.-греч. ἁίμα — «кровь») —
комплексные соединения порфиринов с
железом
https://ru.wikipedia.org/wiki/Гем_(биохимия)
44.
Миоглобин•153 аминокислот
•17 кДа
•по структуре сходен с β-цепью
гемоглобина
•Обладает более высоким сродством к
кислороду по сравнению с
гемоглобином
http://biokhimija.ru/images/biohimija-krov/S12-06-krivye-hb-mb.jpg
Шайтан К. В., Шайтан К. В. Диффузия лигандов в белках //СОЖ. – 2000. – №. 6. – С. 8.
45.
ЦитохромыИзвестно около 30 видов цитохромов. Все они содержат гем в качестве простетической группы и
различаются структурами боковых и полипептидных цепей. В зависимости от типа гема выделяют 8
классов цитохромов. В зависимости от спектров поглощения, цитохромы делят на группы a, b, c
Практически все (кроме цитохрома с) связаны с мембранами
Функционируют во взаимосвязи с ЭТЦ митохондрий или ЭПС
•Цитохромы а
•Цитохромы b
•Цитохром c
•Цитохром P450
46.
47.
ПФП48.
49.
Каталаза (КФ 1.11.1.6)Главный фермент, который расщепляет перекись водорода до
продуктов, не обладающих высокой реактивностью.
Присутствует во всех аэробных клетках, имеет очень высокую
активность и уникальную способность расщеплять перекись
водорода до воды и молекулярного кислорода.
По строению напоминает гемоглобин. Состоит из четырех
одинаковых субъединиц, содержащих гем, железо которого
находится в окисленной форме.
Н2О2 + Н2О2 → 2 Н2О + О2
https://cameralabs.org/media/camera/july/31july/48_e01eb10b0a86df9f7bddf4eb21a261cc.gif
50.
Миелопероксидаза (КФ 1.11.1.7)https://eozin.narod.ru/dima.gif
Биохимия: Учеб. для вузов, Под ред. Е.С. Северина., 2003. 779 с. ISBN 5-9231-0254-4
ОКИСЛИТЕЛЬНЫЙ
МЕТАБОЛИЗМ
АКТИВИРОВАННЫХ
ФАГОЦИТОВ
51.
Ферменты биологического окисленияГидроксипероксидазы
Субстрат - перекись водорода или органические перекиси
52.
ГуанилатциклазыГуанилатциклазы (ГЦ) - семейство ферментов-циклаз,
катализирующих реакцию превращения гуанозинтрифосфата (ГТФ) в
гуанозин-3’,5’-циклофосфат (цГМФ)
Биохимия: Учеб. для вузов, Под ред. Е.С. Северина., 2003. 779 с. ISBN 5-9231-0254-4
53.
Нейрональная NO-синтаза (nNOS или NOS1)Индуцируемая NO-синтаза (iNOS или NOS2)
Эндотелиальная NO-синтаза (eNOS или NOS3 или cNOS)
https://upload.wikimedia.org/wikipedia/commons/d/de/PDB_1m9j_EBI.jpg
Биохимия: Учеб. для вузов, Под ред. Е.С. Северина., 2003. 779 с. ISBN 5-9231-0254-4
NO-синтазы
54.
Сукцинатдегидрогеназаhttps://ru.wikipedia.org/wiki/Сукцинатдегидрогеназа
https://i.pinimg.com/originals/47/5e/61/475e61b8850172da19d0f620a8341061.gif
55.
ЦОГ-1ЦОГ-2
ЦОГ-3?
https://upload.wikimedia.org/wikipedia/commons/e/e6/Cyclooxygenase-2.png
Биохимия: Учеб. для вузов, Под ред. Е.С. Северина., 2003. 779 с. ISBN 5-9231-0254-4
Циклооксигеназы, ЦОГ
56.
Нейроглобинhttps://upload.wikimedia.org/wikipedia/commons/thumb/c/ce/N
euroglobin.png/471px-Neuroglobin.png
Цитоглобин
https://upload.wikimedia.org/wikipedia/commons/6/6f/PBB_Prot
ein_CYGB_image.jpg
57.
https://biokhimija.ru/58.
https://youtu.be/H3DHvJ_MEtkhttps://wellcomelibrary.org/item/b30011851#?c=0&m=0&s=0&cv=0
https://youtu.be/_gkbxvIo_nw
https://youtu.be/bsNlKKFdmrA
https://youtu.be/LWtXthfG9_M
https://youtu.be/Qv-KExGKAYw
https://youtu.be/uWFfRCpHU0Q?list=PL5SFCa6cu2rwgDTRRfvvc88t_B86tBf-0
https://youtu.be/HYbvwMSzqdY
https://youtu.be/BYGPkRFvzOc
https://youtu.be/9ygRzW-oMVk
https://youtu.be/WXOBJEXxNEo
https://youtu.be/u4YGmLhwwkU?list=PL5SFCa6cu2rwgDTRRfvvc88t_B86tBf-0

Химия
Химия








